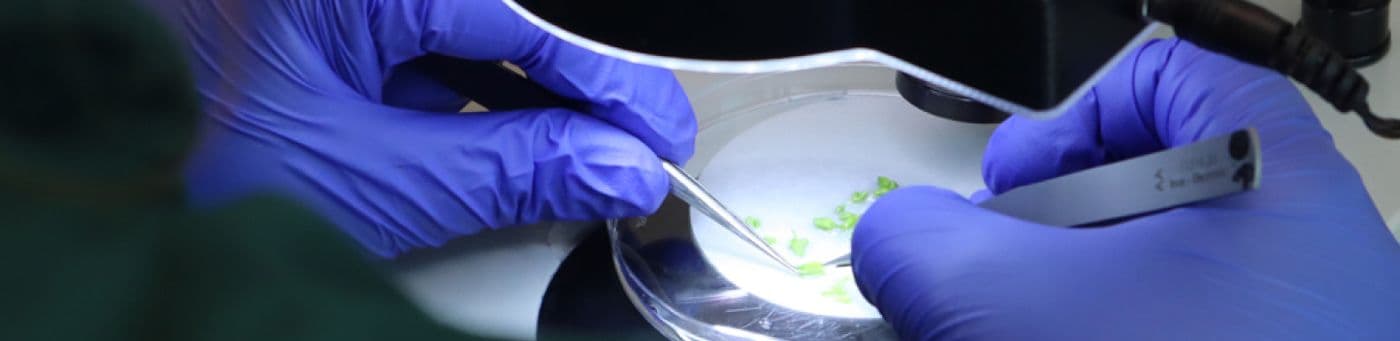

Introduction to Double Haploid Plants
Double haploid techniques, an ‘in vitro’ plant tissue culture technique, offers plant breeders a powerful tool for accelerating variety development. This enables Elsoms to bring better varieties to the grower, quicker. By targeting the anthers, we can facilitate the rapid generation of double haploid plants. This enables plant breeders to develop improved crop varieties with desirable traits such as disease resistance and increased yield potential.
Double Haploid Techniques: A Breakdown
Double haploid production holds immense potential for accelerating the development of new crop varieties. This technique specifically targets the anthers.
The primary objective of double haploid techniques are to produce haploids and double haploid plants. A double haploid (DH) plant is a plant that has two sets of chromosomes (diploid) derived from a single haploid cell. Haploid cells contain only one set of chromosomes, which is half the number found in diploid cells. The production of DH plants is an important technique in plant breeding and genetics.
Advantages of double haploid plants:
Homozygosity: Since DH plants originate from a single haploid cell, they are completely homozygous, meaning both sets of chromosomes are identical. This homozygosity is valuable for producing pure lines in a single generation.
Breeding Efficiency: DH technology accelerates the breeding process, allowing breeders to develop new varieties more quickly compared to traditional methods that require several generations to achieve homozygosity.
Genetic Studies: DH plants are useful for genetic mapping and other studies because their genetic makeup is uniform and stable.

The process
Our lab team meticulously selects flower buds, isolating the anthers with pollen at precise developmental stages and placing them onto a specific medium tailored to stimulate microspore development. Under controlled conditions of temperature and light, the microspores within the anthers undergo division, eventually giving rise to embryos. These embryos can then be grown into diploid plants, later used for breeding.
Utilising Double Haploid Plants in Breeding Programs
The beauty of double haploid techniques lie in their ability to generate a diverse array of haploid/double haploids plants in a relatively short period. These plants serve as invaluable genetic resources for our breeding programs, offering a treasure trove of traits and genetic combinations.

Once double haploid plants are obtained, our breeders embark on a journey of selection and hybridisation, crossing them with elite parental lines to create hybrid varieties with enhanced characteristics. Through meticulous testing and evaluation, we ensure that only the most promising varieties make it to market, meeting our stringent criteria for distinctiveness, uniformity, and stability.
Providing Farmers with Superior Crop Varieties
The impact of double haploid plants extends far beyond the laboratory walls. By harnessing the power of modern breeding techniques, we're providing farmers with resilient, high-performing crop varieties that thrive in diverse environments. From disease resistance to increased yield potential, the possibilities are endless.